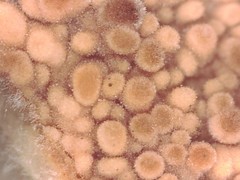
Thelephora aurantiotincta

Thelephora aurantiotincta: taxon details and analytics
- Domain
- Kingdom
- Fungi
- Phylum
- Basidiomycota
- Class
- Agaricomycetes
- Order
- Thelephorales
- Family
- Thelephoraceae
- Genus
- Thelephora
- Species
- Thelephora aurantiotincta
- Scientific Name
- Thelephora aurantiotincta
Thelephora aurantiotincta in languages:
- Chinese
- 橙黃革菌
- Japanese
- ボタンイボタケ
Images from inaturalist.org observations:
We recommend you sign up for this excellent, free service.
Parent Taxon
Sibling Taxa
- Thelephora albidobrunnea
- Thelephora americana
- Thelephora anthocephala
- Thelephora arbuscula
- Thelephora atra
- Thelephora aurantiotincta
- Thelephora caespitulans
- Thelephora caryophyllea
- Thelephora cervicornis
- Thelephora congesta
- Thelephora cuticularis
- Thelephora ganbajun
- Thelephora griseozonata
- Thelephora intybacea
- Thelephora investiens
- Thelephora multipartita
- Thelephora palmata
- Thelephora penicillata
- Thelephora ramarioides
- Thelephora regularis
- Thelephora rosella
- Thelephora scissilis
- Thelephora terrestris
- Thelephora vialis